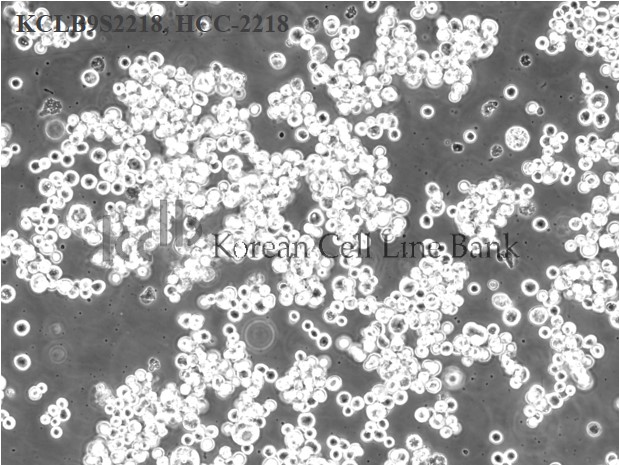
HCC-2218

HCC-2218
| KCLB NO |
9S2218
|
|---|---|
| Name |
HCC-2218
|
세포주 분양조건
서비스
수량
-
+
| Origin |
breast
|
|---|---|
| Species |
human female, 38 years old, white
|
| Cellular morphology |
epithelial
|
| Growth Pattern |
suspension, floating aggregates
|
| Histopathology |
ductal cancer
|
| Depositor |
Adi F Gazdar
|
| D3S1358 |
16
|
|---|---|
| vWA |
14,18
|
| FGA |
24
|
| Amelogenin |
X
|
| TH01 |
8,9.3
|
| TPOX |
8
|
| CSF1P0 |
11
|
| D5S818 |
11
|
| D13S317 |
11,12
|
| D7S820 |
14
|

준비중입니다.
| freeze media |
RPMI1640, 52.5%; FBS, 40%; DMSO, 7.5%
|
|---|---|
| original medium |
RPMI1640 with L-glutamine (300mg/L), 25mM HEPES and 25mM NaHCO3, 90%; heat inactivated fetal bovine serum (FBS), 10%
|
| kclb media |
RPMI1640 with L-glutamine (300mg/L), 25mM HEPES and 25mM NaHCO3, 90%; heat inactivated fetal bovine serum (FBS), 10%
|
| subculturing |
Remove medium, add fresh 0.25 % trypsin 0.02 % EDTA solution, stand culture flask at 37
|
| media change |
Remove two thirds of medium and add fresh medium (depending on cell density) every 2 to 3 days
|
|
Gazdar et al., Characterization of paired tumor and non-tumor cell lines established from patients with breast cancer, Int J Cancer, 1998, 78:766-774
|
|
|---|---|
|


